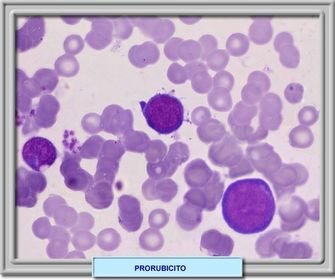
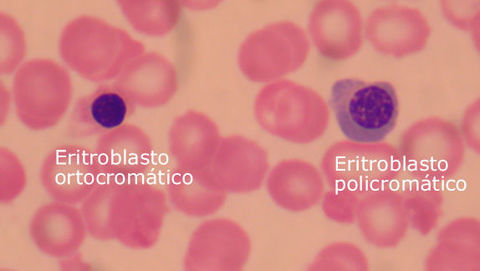
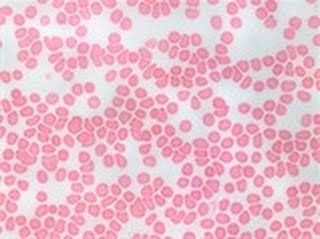

Fichas sobre eritropoyesis
Pinned to
2221
0
0
No tags specified
|
|
Created by Claudia Duarte
about 10 years ago
|
|
Close
|
|
Created by Claudia Duarte
about 10 years ago
|
|

HEMATOPOYESIS
ERITROPOYESIS
Es la proliferación de las células rojas, se da en saco vitelino e hígado en la fase prenatal y en médula ósea en adultos, son de origen mieloide y el factor estimulado es la eritropoyetina.

ERITROPOYETINA
Es una glucoproteína sintetizada en los riñones e hígado. Su principal función es la estimulación de síntesis de eritrocitos en la médula ósea. En su estructura posee:
- Unidades de carbohidratos (34%): sitio de unión a los receptores de las células blanco.
- Unidad de ácido siálico (10 - 15%): actividad biológica de la macromolécula.
CÉLULAS TRONCALES HEMATOPOYÉTICAS
Son células primitivas, se encuentran en la médula ósea, tienen características que las diferencian: son capaces de regenerarse, dividirse y son multipotenciales. Dan origen a las células progenitoras hematopoyéticas.
CÉLULAS PROGENITORAS HEMATOPOYÉTICAS
Son células que han perdido su capacidad de renovación, pero conservan su potencial proliferativo. Pueden ser multipotenciales o restringirse a un solo linaje de células, puede ser mieloide o linfática.
Proeritroblasto/ Pronormoblasto/ Rubiblasto

Solo se encuentran en médula ósea, son células con actividad mitótica.

Eritroblasto basófilo/ Normoblasto basófilo/ Prorubicito
El citoplasma es más basófilo que en el proeritroblasto y el núcleo más pequeño.
Normalmente se encuentra en la médula ósea.

Eritoblasto policromatófilo/ Normoblasto policromatófilo/ Rubricito

Su ubicación normalmente es en médula ósea.

Eritroblasto ortoctomático/ Normoblasto ortocromático/ Metarubricito

La diferencia más evidente con el eritroblasto policromatófilo está en el tamaño del núcleo y la acidofília del citoplasma dada por la Hb.

Reticulocito/ Eritrocito policromático/ Eritrocito difusamente basófilo

La diferenciación del resto de células lo da el reducido tamaño celular, la acidofilia del citoplasma y los restos de ARN son la principal característica diferencial.

Eritrocito/ Hematíe/ Célula roja
La principal diferencia con los reticulocitos es la pérdida de los restos de ARN y organelas.


 Hide known cards
Hide known cards